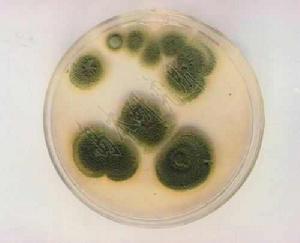
洛克菲特青黴 洛克菲特青黴

乾酪
乾酪又稱乳酪,是一種乳濃縮物,其基礎乾物質主要是蛋白質(實際是酪蛋白)和脂肪,液體稱為乳清。在生產硬質乾酪和一些半硬質乾酪時,乳中的酪蛋白和脂肪被濃縮約十倍。根據是否需要成熟分為兩類:一類不經過發酵成熟,稱為新鮮乾酪;另一類經過長時間的發酵成熟,稱為成熟乾酪。乾酪營養成分豐富,蛋白質和脂肪的含量較原料乳提高了10倍。此外,乾酪中所含有的鈣、磷等無機鹽成分,除了能滿足人體基本的營養需要,還具有重要的生理功能。乾酪中含有較多的脂溶性維生素,維生素A的含量最高。
乾酪的分類
根據凝乳方法不同,通常將乾酪劃分為以下四個類型:
(1)凝乳酶凝乳的乾酪
大多數品種的乾酪都屬於此種類型;
(2)酸凝乳的乾酪
如稀奶油乾酪、農家乾酪和夸克乾酪;
(3)酸/熱聯合凝乳的乾酪
如里科塔(Ricotta)乾酪;
(4)濃縮或結晶方法處理的乾酪
如挪威乳清乾酪麥索斯特(Mysost)。
由於利用凝乳酶凝乳製作的乾酪品種之間仍然有很大差異,一般根據其工藝技術或成熟因素(內部黴菌、內部細菌、表面黴菌、表面細菌等)再進一步分類。
洛克菲特青黴菌
在乳品加工中,洛克菲特青黴菌(Penicilliumroqueforti)是占有重要地位的發酵劑菌種之一。它能夠代謝生成CO2和多種風味化合物,並且具有潛在的益生效果,常被用於發酵乳、黃油以及乾酪的發酵生產。將洛克菲特青黴菌其作為發酵劑菌種或非發酵劑乳酸菌(NSLAB)套用到發酵乳製品當中,將會在很大程度上提高產品的感觀質量或功能性效果。然而目前國內尚沒有洛克菲特青黴菌參與發酵的乳製品問世,因此選育具有優良性狀的洛克菲特青黴菌菌種,將會在很大程度上促進國內發酵乳製品種類的多樣化,同時提高產品的感觀質量和功能效果。
洛克菲特乾酪
洛克菲特乾酪(Roquefort)首次被記載於1070年,按照凝乳方法屬於凝乳酶凝乳的乾酪,由黴菌發酵成熟,發酵菌洛克菲特青黴接種於乾酪內部。此外,德納布魯乾酪和哥跟索拉乾酪也屬於此類乾酪。
洛克菲特青黴菌在乳品技術中的套用
對於藍紋乾酪(blue-vinedcheese)以及由洛克菲特青黴菌(Penicilliumroqueforti)參與發酵生產的洛克菲特乾酪(Roquefortcheese)而言,乾酪組織內部孔眼的大小及形狀等特點都是檢測其質量的重要指標。對於軟質熟化乾酪而言,凝乳結構具有較高的韌性,不易塌陷,所以加工過程當中除採用機械打孔的方式之外,還可以利用洛克菲特青黴菌代謝生成的CO2氣體在乾酪凝塊內部產生孔眼。對於壓榨熟化的荷蘭乾酪(Dutchcheese)而言,如Edam乾酪、Gouda乾酪或其它鹽水浸漬乾酪品種,微小細密的孔眼主要是由於洛克菲特青黴菌產生的CO2氣體所引起。對於此類乾酪產品而言,應儘量選擇CO2生成量適中的菌株,以避免產氣過多造成網眼過多的現象。
在洛克菲特乾酪當中,洛克菲特青黴菌細胞數量通常占乳酸球菌的5%~10%左右。例如,對於含5×10^7cfu/mL乳酸球菌的乳而言,洛克菲特青黴菌最低細胞數量約為10^6cfu/mL。乾酪生產中,當採用腸膜洛克菲特青黴菌腸膜亞種的濃縮細胞懸浮液作為發酵劑時,通常可以在產品中獲得較高的細胞數量。此外,少數情況下,乳中原有的或來自於環境的洛克菲特青黴菌細胞也可以使乾酪產生足夠數量的孔眼結構。但是,當採用巴氏消毒的原料乳或者衛生質量很高的生乳(這意味著生乳中洛克菲特青黴菌自然存在的細菌細胞數量極少)加工乾酪時,則需要添加洛克菲特青黴菌發酵劑來提高幹酪質量。儘管洛克菲特青黴菌在每公斤乾酪中產生的CO2最大濃度是16mmol/kg(相當於原料乳中8mmol/L的檸檬酸被消耗掉),但是此種代謝活性隨著洛克菲特青黴菌種(或株)的不同而存在明顯的差異。
在傳統的乾酪加工過程中,30°C的加工條件顯然不利於洛克菲特青黴菌的存活,這便要求菌株具有較高的耐熱特性,才能夠在乾酪生產初期(即壓榨階段)保持穩定的細胞生長能力;並且它們應該能經受乾酪加工過程中各種不利條件而存活,以便在生產後期的熟化階段,繼續完成檸檬酸代謝過程。相反,對於用水洗步驟處理的乾酪品種而言,那些只有在低pH值下才具有代謝活性的菌株極有可能失去活力,其原因在於水洗處理後的凝乳塊中pH明顯提高,導致這些菌株代謝活力降低。研究表明,洛克菲特青黴菌總是參與某些乾酪品種早期或後期的膨脹過程(blowing)。人們發現,像荷蘭高達乾酪品系(Gouda-type)中的挪威乾酪,9種乾酪產品中的7種都具有孔眼結構,並且均由洛克菲特青黴菌參與形成。